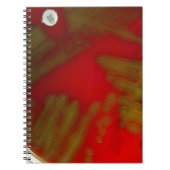
Penumonia Bacteria Notitieboek (Voorkant)

Over Notitieboekjes
Aangeboden door
Over dit ontwerp
Penumonia Bacteria Notitieboek
Een streak bord van Streptococcus pneumoniae met een optochine antibioticum schijf erop. De bord shows alfa hemoloysis op het bloedagar bord.
Ontwerp van international designer
Klant beoordelingen
4.0 van 5 sterren beoordeling1 aantal beoordelingen
1 Reviews
Beoordelingen voor identieke producten
4 van 5 sterren beoordeling
Door E.25 november 2023 • Geverifieerde aankoop
16,5 x 22,2 cm klassiek notitieboek
Zazzler recensent programma
Perfect zoals verwacht. Mooi precies zoals gedacht
Tags
Andere Info
Product ID: 130262507079714533
Ontworpen op: 24-12-2013 8:42
Rating: G
Recent bekeken items